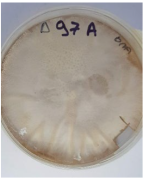
Applsci 12 08918 i003
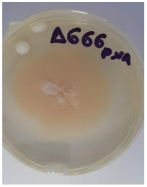
Applsci 12 08918 i005

Potential Use of Fusarium Isolates as Biological Control Agents: Helicoverpa armigera (Hübner) (Lepidoptera: Noctuidae) Case Study
Abstract
:1. Introduction
2. Materials and Methods
2.1. Collection, Isolation, and Identification of Fusarium
2.1.1. Sample Collection and Fungal Isolation
2.1.2. Morphology of Isolated Fungi
2.1.3. DNA Extraction, PCR Amplification and Sequence Analysis
2.2. Insects
Bioassays
2.3. Statistical Analysis
3. Results
4. Discussion
Author Contributions
Funding
Institutional Review Board Statement
Informed Consent Statement
Data Availability Statement
Conflicts of Interest
References
- Talekar, N.S.; Opena, R.T.; Hanson, P. Helicoverpa armigera management: A review of AVRDC’s research on host plant resistance in tomato. Crop Prot. 2006, 25, 461–467. [Google Scholar] [CrossRef]
- Pinto, F.A.; Mattos, M.V.; Silva, F.W.; Rocha, S.L.; Elliot, S.L. The spread of Helicoverpa armigera (Lepidoptera: Noctuidae) and coexistence with Helicoverpa zea in Southeastern Brazil. Insects 2017, 8, 87. [Google Scholar] [CrossRef] [PubMed]
- Akbulut, S.; Yuksel, B.; Keten, A. The Lepidoptera (INSECTA) Fauna of Düzce Province, Turkey. Turk. J. Zool. 2003, 27, 257–268. [Google Scholar]
- Moral Garcia, F.J. Analysis of the spatiotemporal distribution of Helicoverpa armigera (Hübner) in a tomato field using a stochastic approach. Biosyst. Eng. 2006, 93, 253–259. [Google Scholar] [CrossRef]
- Fitt, G.P. The ecology of Heliothis species in relation to agroecosystems. Ann. Rev. Entomol. 1989, 34, 17–53. [Google Scholar] [CrossRef]
- Liu, Z.; Li, D.; Gong, P.; Wu, K. Life table studies of the cotton bollworm, Helicoverpa armigera (Hübner) (Lepidoptera: Noctuidae), on different host plants. Environ. Entomol. 2004, 33, 1570–1576. [Google Scholar] [CrossRef]
- Gunning, R.V.; Easton, C.S.; Balfe, M.E.; Ferris, I.G. Pyrethroid resistance mechanisms in Australian Helicoverpa armigera. Pestic. Sci. 1991, 33, 473–490. [Google Scholar] [CrossRef]
- Martin, T.; Ochou, G.O.; Djihinto, A.; Traore, D.; Togola, M.; Vassal, J.M.; Vaissayre, M.; Fournier, D. Controlling an insecticide-resistant bollworm in West Africa. Agric. Ecosyst. Environ. 2005, 107, 409–411. [Google Scholar] [CrossRef]
- Mironidis, G.K.; Kapantaidaki, D.; Bentila, M.; Morou, E.; Savopoulou-Soultani, M.; Vontas, J. Resurgence of the cotton bollworm Helicoverpa armigera in northern Greece associated with insecticide resistance. Insect Sci. 2013, 20, 505–512. [Google Scholar] [CrossRef]
- Riaz, S.; Johnson, J.B.; Ahmad, M.; Fitt, G.P.; Naiker, M. A review on biological interactions and management of the cotton bollworm, Helicoverpa armigera (Lepidoptera: Noctuidae). J. Appl. Entomol. 2021, 145, 467–498. [Google Scholar] [CrossRef]
- Schöller, M.; Flinn, P.W.; Grieshop, M.J.; Zdarkova, E. Biological control of stored product pests. In Insect Management for Food Storage and Processing; Heaps, J.E., Ed.; AACC International Press: St. Paul, MN, USA, 2006; pp. 67–87. [Google Scholar]
- Weinzierl, R.; Higgins, R. Insect pest management for stored grain. In Illinois Agricultural Pest Management Handbook: Serving Agriculture and the Environment; Cooperative Extension Service College of Agriculture, University of Illinois at Urbana-Champaign: Champaign, IL, USA, 2008; pp. 147–156. [Google Scholar]
- Shafighi, Y.; Ziaee, M.; Ghosta, Y. Diatomaceous earth used against insect pests, applied alone or in combination with Metarhizium anisopliae and Beauveria bassiana. J. Plant Prot. Res. 2014, 54, 62–66. [Google Scholar] [CrossRef]
- Arora, A.; Saha, L.K.; Marwaha, S.; Jain, R.; Jha, A.K. Online system for Integrated Pest Management on tomato in AGRIdaksh. In Proceedings of the 2015 2nd International Conference on Computing for Sustainable Global Development, New Delhi, India, 11–13 March 2015; Hoda, M., Ed.; Institute of Electrical and Electronics Engineers (IEEE): New York, NY, USA, 2015; pp. 1125–1129. [Google Scholar]
- Cox, P.D.; Wilkin, D.R. The potential use of biological control of pests in stored grain. In HGCA Research Review, 36; HGCA: London, UK, 1996; pp. 1–53. [Google Scholar]
- Batta, Y.A.; Kavallieratos, N.G. The use of entomopathogenic fungi for the control of stored-grain insects. Int. J. Pest Manag. 2008, 64, 77–87. [Google Scholar] [CrossRef]
- Moore, D.; Lord, J.C.; Smith, S.M. Pathogens. In Alternatives to Pesticides in Stored-Product IPM; Subramanyam, B., Hagstrum, D.W., Eds.; Kluwer Academic Press: Dordrecht, The Netherlands, 2012; pp. 193–227. [Google Scholar]
- Aoki, T.; O’Donnell, K.; Geiser, D.M. Systematics of key phytopathogenic Fusarium species: Current status and future challenges. J. Gen. Plant Pathol. 2014, 80, 189–201. [Google Scholar] [CrossRef]
- Sharma, L.; Marques, G. Fusarium, an entomopathogen—A myth or reality? Pathogens 2018, 7, 93. [Google Scholar] [CrossRef]
- Addario, E.; Turchetti, T. Parasitic fungi on Dryocosmus kuriphilus in Castanea sativa necrotic galls. Bull. Insectol. 2011, 64, 269–273. [Google Scholar]
- Fan, J.H.; Xie, Y.P.; Xue, J.L.; Xiong, Q.; Jiang, W.J.; Zhang, Y.J.; Ren, Z.M. The strain HEB01 of Fusarium sp., a new pathogen that infects brown soft scale. Ann. Microbiol. 2014, 64, 333–341. [Google Scholar] [CrossRef]
- Liu, W.; Xie, Y.; Dong, J.; Xue, J.; Zhang, Y.; Lu, Y.; Wu, J. Pathogenicity of three entomopathogenic fungi to Matsucoccus matsumurae. PLoS ONE 2014, 9, e103350. [Google Scholar] [CrossRef]
- Anwar, W.; Haider, M.S.; Shahid, A.A.; Mushtaq, H.; Hameed, U.; Rehman, M.Z.U.; Iqbal, M.J. Genetic diversity of Fusarium isolated from members of Sternorrhyncha (Hemiptera): Entomopathogens against Bemisia tabaci. Pak. J. Zool. 2017, 49, 639–645. [Google Scholar] [CrossRef]
- Liuzzi, V.C.; Mirabelli, V.; Cimmarusti, M.T.; Haidukowski, M.; Leslie, J.F.; Logrieco, A.F.; Caliandro, R.; Fanelli, F.; Mulè, G. Enniatin and beauvericin biosynthesis in Fusarium species: Production profiles and structural determinant prediction. Toxins 2017, 9, 45. [Google Scholar] [CrossRef]
- Wang, Q.; Xu, L. Beauvericin, a bioactive compound produced by fungi: A short review. Molecules 2012, 17, 2367–2377. [Google Scholar] [CrossRef]
- Caloni, F.; Fossati, P.; Anadón, A.; Bertero, A. Beauvericin: The beauty and the beast. Environ. Toxicol. Pharmacol. 2020, 75, 103349. [Google Scholar] [CrossRef] [PubMed]
- Mallebrera, B.; Prosperini, A.; Font, G.; Ruiz, M.J. In vitro mechanisms of Beauvericin toxicity: A review. Food Chem. Toxicol. 2018, 111, 537–545. [Google Scholar] [CrossRef]
- Batta, Y.A. The first report on entomopathogenic effect of Fusarium avenaceum (Fries) Saccardo (Hypocreales, Ascomycota) against rice weevil (Sitophilus oryzae L.: Curculionidae, Coleoptera). J. Entomol. Acarol. Res. 2012, 44, 51–55. [Google Scholar] [CrossRef]
- Kuruvilla, S.; Jacob, A. Studies on Fusarium oxysporum Schlect infecting rice brown plant hopper Nilaparvata lugens Stal [India]. Agric. Res. J. Kerala 1980, 18, 51–54. [Google Scholar]
- Teetor-Barsch, G.H.; Roberts, D.W. Entomogenous Fusarium species. Mycopathologia 1983, 84, 3–16. [Google Scholar] [CrossRef] [PubMed]
- Mikunthan, G.; Manjunatha, M. Fusarium semitectum, a potential mycopathogen against thrips and mites in chilli, Capsicum annuum. Commun. Agric. Appl. Biol. Sci. 2006, 71, 449–463. [Google Scholar] [PubMed]
- Quesada-Moraga, E.; Navas-Cortés, J.A.; Maranhao, E.A.; Ortiz-Urquiza, A.; Santiago-Álvarez, C. Factors affecting the occurrence and distribution of entomopathogenic fungi in natural and cultivated soils. Myc. Res. 2007, 111, 947–966. [Google Scholar] [CrossRef] [PubMed]
- Summeral, B.A.; Salleh, B.; Leslie, J.F. A utilitarian approach to Fusarium identification. Plant Dis. 2003, 87, 117–128. [Google Scholar] [CrossRef]
- Rogers, S.O.; Bendich, A.J. Extraction of DNA from milligram amounts of fresh, herbarium and mummified plant tissues. Plant Mol. Biol. 1985, 5, 69–76. [Google Scholar] [CrossRef]
- Chitti Babu, G.; Sharma, H.C.; Madhumati, T.; Raghavaiah, G.; Murthy, K.V.M.K.; Rao, V.S. A semi-synthetic chickpea flour based diet for long-term maintenance of laboratory culture of Helicoverpa armigera. Ind. J. Entomol. 2014, 76, 336–340. [Google Scholar]
- Mantzoukas, S. The effect of Metarhizium robertsii and Bacillus thuringiensis against Helicoverpa armigera (Hübner) (Lepidoptera: Noctuidae). Adv. Ecol. Environ. Res. 2019, 4, 136–146. [Google Scholar]
- Strasser, H.; Vey, A.; Butt, T.M. Are there any risks in using entomopathogenic fungi for pest control, with particular reference to the bioactive metabolites of Metarhizium, Tolypocladium and Beauveria species? Biocontrol Sci. Technol. 2000, 10, 717–735. [Google Scholar] [CrossRef]
- Zimmermann, G. Review on safety of the entomopathogenic fungi Beauveria bassiana and Beauveria brongniartii. Biocontrol Sci. Technol. 2007, 17, 553–596. [Google Scholar] [CrossRef]
- Zimmermann, G. Review on safety of the entomopathogenic fungus Metarhizium anisopliae. Biocontrol Sci. Technol. 2007, 17, 879–920. [Google Scholar] [CrossRef]
- Mantzoukas, S.; Eliopoulos, P.A. Endophytic entomopathogenic fungi: A valuable biological control tool against plant pests. Appl. Sci. 2020, 10, 360. [Google Scholar] [CrossRef] [Green Version]
- Vega, F.E.; Goettel, M.S.; Blackwell, M.; Chandler, D.; Jackson, M.A.; Keller, S.; Koike, M.; Maniania, N.K.; Monzon, A.; Ownley, B.H.; et al. Fungal entomopathogens: New insights on their ecology. Fungal Ecol. 2009, 2, 149–159. [Google Scholar] [CrossRef]
- Ghazavi, M.; Abaii, M.; Zangeneh, S. New records of some entomopathogenic fungi from Iran. Rostaniha 2006, 6, 119–130. [Google Scholar]
- Cortez-Madrigal, H.; Alatorre-Rosas, R.; Mora-Aguilera, G.; Bravo-Mojica, H.; Ortiz-Garcia, C.F.; Aceves-Navarro, L.A. Characterization of multisporic and monosporic isolates of Lecanicillium (=Verticillium) lecanii for the management of Toxoptera aurantii in cocoa. Biocontrol 2003, 48, 321–334. [Google Scholar] [CrossRef]
- Kalvnadi, E.; Mirmoayedi, A.; Alizadeh, M.; Pourian, H.R. Sub-lethal concentrations of the entomopathogenic fungus, Beauveria bassiana increase fitness costs of Helicoverpa armigera (Lepidoptera: Noctuidae) offspring. J. Invertebr. Pathol. 2018, 158, 32–42. [Google Scholar] [CrossRef]
- Khoobdel, M.; Pourian, H.R.; Alizadeh, M. Bio-efficacy of the indigenous entomopathogenic fungus, Beauveria bassiana in conjunction with desiccant dust to control of coleopteran stored product pests. J. Invertebr. Pathol. 2019, 168, 107254. [Google Scholar] [CrossRef]
- Inglis, D.G.; Goette, M.S.; Butt, T.M.; Strasser, H. Use of Hyphomycetous Fungi. In Fungi as Biocontrol Agents; Butt, T.M., Jackson, C., Magan, N., Eds.; CABI Publishing: Oxfordshire, UK, 2019; pp. 23–69. [Google Scholar]
- Roy, H.E.; Steinkraus, D.C.; Eilenberg, J.; Hajek, A.E.; Pell, J.K. Bizarre interactions and endgames: Entomopathogenic fungi and their arthropod hosts. Annu. Rev. Entomol. 2006, 51, 331–357. [Google Scholar] [CrossRef] [PubMed]
- Pourian, H.R.; Alizadeh, M. Diatomaceous earth low-lethal dose effects on the fitness of entomopathogenic fungus, Beauveria bassiana, against two coleopteran stored product pests. J. Stored Prod. Res. 2021, 94, 101878. [Google Scholar] [CrossRef]
- Eleonora-Rojas, M.; Perea, E.I.; Pineda, Y.A. Fusarium species on Trialeurodes vaporariorum from tobacco and kidney bean of Garcia Rovera, Santander, Colombia. Revista Colomb. Entomol. 2003, 29, 1–10. [Google Scholar]
- Strunz, G.M.; Strongman, D.B. Insecticidal Metabolites from Fusarium avenaceum, a Fungus Associated with Foliage of Abies balsamea Infested by Spruce Budworm, Choristoneura fumiferana. In Biotechnology for Crop Protection, ACS Symposium Series; Hedin, P.A., Menn, J.J., Hollingworth, R.M., Eds.; American Chemical Society: Washington, DC, USA, 1988; Volume 379, pp. 110–116. [Google Scholar]
- Sun, Z. The pathogenicity of Fusarium spp. to Wheat Stem Sawfly, Cephus cinctus Norton (Hymenoptera: Cephidae). Ph.D. Thesis, Montana State University, Bozeman, MT, USA, 2008. [Google Scholar]
- Anand, R.; Tiwary, B.N. Pathogenicity of entomopathogenic fungi to eggs and larvae of Spodoptera litura, the common cutworm. Biocontrol Sci. Technol. 2009, 19, 919–929. [Google Scholar] [CrossRef]
- da Silva Santos, A.C.; Diniz, A.G.; Tiago, P.V.; de Oliveira, N.T. Entomopathogenic Fusarium species: A review of their potential for the biological control of insects, implications and prospects. Fungal Biol. Rev. 2020, 34, 41–57. [Google Scholar] [CrossRef]
- Logrieco, A.; Rizzo, A.; Ferracane, R.; Ritieni, A. Occurrence of beauvericin and enniatins in wheat affected by Fusarium avenaceum head blight. Appl. Environ. Microbiol. 2002, 68, 82. [Google Scholar] [CrossRef]
- Thrane, U. Screening for fusarin C production by European isolates of Fusarium species. Mycotoxin Res. 1988, 4, 2–10. [Google Scholar] [CrossRef]
- Abbas, H.K.; Mirocha, C.J.; Gunther, R. Mycotoxins produced by toxic Fusarium isolates obtained from agricultural and nonagricultural Arctic areas of Norway. Mycopathologia 1989, 105, 143–152. [Google Scholar] [CrossRef]
- Rabie, C.J.; Marasas, W.F.O.; Thiel, P.G.; Lübben, A.; Vleggaar, R. Moniliformin production and toxicity of different Fusarium species from southern Africa. Appl. Environ. Microbiol. 1982, 43, 517–521. [Google Scholar] [CrossRef]
- Chelkowski, J.; Zawadzki, M.; Zajkowski, P.; Logrieco, A.; Bottalico, A. Moniliformin production by Fusarium species. Mycotoxin Res. 1990, 6, 41–45. [Google Scholar] [CrossRef]
- Haschek, W.M.; Gumprecht, L.A.; Smith, G.; Tumbleson, M.E.; Constable, P.D. Fumonisin toxicosis in swine: An overview of porcine pulmonary edema and current perspectives. Environ. Health Perspect. 2001, 109 (Suppl. S2), 251–257. [Google Scholar]
- Forrester, N.W.; Cahill, M.; Bird, L.J.; Layland, J.K. Management of pyrethroid and endosulfan resistance in Helicoverpa armigera (Lepidoptera: Noctuidae) in Australia. Bull. Entomol. Res. Suppl. Ser. 1993, 1–133. [Google Scholar]
- Yang, Y.; Li, Y.; Wu, Y. Current status of insecticide resistance in Helicoverpa armigera after 15 years of Bt cotton planting in China. J. Econ. Entomol. 2013, 106, 375–381. [Google Scholar] [CrossRef]
- Ganassi, S.; Moretti, A.; Stornelli, C.; Fratello, B.; Bonvicini Pagliai, A.M.; Logrieco, A.; Sabatini, M.A. Effect of Fusarium, Paecilomyces and Trichoderma formulations against aphid Schizaphis graminum. Mycopathologia 2001, 151, 131–138. [Google Scholar] [CrossRef]
- Hussain, A.; Tian, Μ.; He, Y.; Ahmed, S. Entomopathogenic fungi disturbed the larval growth and feeding performance of Ocinara varians (Lepidoptera: Bombycidae) larvae. Insect Sci. 2009, 16, 511–517. [Google Scholar] [CrossRef]
- Ferron, P.; Fargues, J.; Riba, G. Fungi as microbial insecticides against pests. In Handbook of Applied Mycology; Arora, D.K., Ajello, L., Mukerji, K.G., Eds.; Marcel Dekker: New York, NY, USA, 1991; pp. 665–706. [Google Scholar]
- Soderhäll, K.; Ajaxon, R. Effect of quinones and melanin on mycelial growth of Aphanomyces spp. and extracellular protease of Aphanomyces astaci, a parasite of crayfish. J. Invertebr. Pathol. 1982, 39, 105–109. [Google Scholar] [CrossRef]
- Adsure, S.P.; Mohite, P.B. Efficacy of entomopathogenic fungi against gram pod borer, Helicoverpa armigera (Hub.) on chickpea. J. Glob. Biosc. 2015, 4, 3154–3157. [Google Scholar]
- Prasad, A.; Syed, N. Evaluating prospects of fungal biopesticide Beauveria bassiana (Balsamo) against Helicoverpa armigera (Hubner): An ecosafe strategy for pesticidal pollution. Asian J. Exp. Biol. Sci. 2010, 1, 596–601. [Google Scholar]
- Ebrahimi, L.; Shiri, M.; Dunphy, G.B. Effect of entomopathogenic nematode, Steinernema feltiae, on survival and plasma phenoloxidase activity of Helicoverpa armigera (Hb) (Lepidoptera: Noctuidae) in laboratory conditions. Egypt. J. Biol. Pest Control 2018, 28, 12. [Google Scholar] [CrossRef]
- Majeed, M.Z.; Riaz, M.A.; Khan, M.A.; Ma, C.S.; Ahmad, S. Pathogenicity of indigenous soil isolate of Bacillus thuringiensis to Helicoverpa armigera Hübner 1809 (Lepidoptera: Noctuidae). Egypt. J. Biol. Pest Control 2018, 28, 38. [Google Scholar] [CrossRef]
- Mishra, R.K.; Sobita, S. Efficacy of Beauveria bassiana against gram pod borer (Helicoverpa armigera Hubner) of chickpea (Cicer arietinum Linn.). New Agric. 2012, 23, 255–259. [Google Scholar]
| Stage 1 | Biological yeast powder (60 g), sucrose (60 g), formaldehyde 10% (15 mL), choline chloride 20% (30 mL), distilled water (1200 mL). |
| Stage 2 | Ascorbic acid (12 g), methyl 4 hydroxy benzoate (7.5 g), sorbic acid (4.5 g), streptomycine sulphate (0.1 g), cholesterol (0.6 g), wheat germ oil (0.6 mL) and vitamin mixture (0.6 g). Section 3 includes agar (45 g) and distilled water (1000 mL). |
| Stage 3 (Vitamin Mixture) | Micotineacitamide (9.30 g), riboflavin (4.64 g), pyridoxine hydrochloride (2.32 g), biotin (0.18 g), vitamin B12 (0.01 g), folic acid (4.64 g) and thiamine hydrochloride (2.32 g). |
| Fungal Species | Isolate | Insect Bait | Collection Site | Request ID | ID Match (%) (NCBI BLAST) | Photo |
|---|---|---|---|---|---|---|
| F. solani | Δ99Β | Sitophilus granarius | Dassylio Achaia | TYPX96JD016 | 98.73 | ![]() |
| F. chlamydosporum var chlamydosporum | Ε103 | Tribolium confusum | Elos Agias Patra | TYZV90RD016 | 98.55 | ![]() |
| F. tonkinense | Δ97A | Sitophilus granarius | Dassylio Achaia | TYTTA1TV01R | 100 | ![]() |
| F. longifundum | Δ141 | Sitophilus granarius | Dassylio Achaia | TYTWYJE2013 | 99.62 | ![]() |
| F. pseudoanthophilum | Δ666 | Tribolium confusum | Dassylio Achaia | TYW8XYVE013 | 99.43 | ![]() |
| F. fujikuroi | 2Ε187 | Sitophilus granarius | Elos Agias Patra | TYVNJ10A013 | 99.83 | ![]() |
| F. algeriense | Δ557 | Tribolium confusum | Dassylio Achaia | TYV2VNSW013 | 99.88 | ![]() |
| Treatment | Concentration | Exposure Time | Median Lethal Time | ||
|---|---|---|---|---|---|
| 72 HAT | 144 HAT | 216 HAT | |||
| F. solani | 103 | 0.0 ± 0.0 c | 17.0 ± 5.8 c | 30.0 ± 10.0 c | 203.3 ± 1.2 a |
| 104 | 0.0 ± 0.0 c | 23.0 ± 5.8 c | 43.0 ± 5.8 c | 198.2 ± 2.3 b | |
| 105 | 3.4 ± 5.8 c | 30.0 ± 15.3 bc | 67.0 ± 5.8 b | 169.5 ± 1.8 c | |
| 106 | 13.4 ± 5.8 b | 33.0 ± 10.0 b | 80.0 ± 10.0 a | 137.7 ± 2.1 d | |
| 107 | 20.0 ± 10.0 a | 43.0 ± 11.5 a | 89.0 ± 11.5 a | 100.0 ± 0.8 e | |
| 108 | 33.0 ± 15.3 a | 53.0 ± 15.3 a | 91.0 ± 5.8 a | 95.0 ± 1.4 f | |
| Control | H2O + Tergitol Np9 | 0.0 ± 0.0 c | 2.7 ± 1.3 d | 2.7 ± 1.3 d | 215.0 ± 0.2 g |
| Treatment | Concentration | Exposure Time | Median Lethal Time | ||
|---|---|---|---|---|---|
| 72 HAT | 144 HAT | 216 HAT | |||
| F. chlamydosporum var. chlamydosporum | 103 | 0.0 ± 0.0 c | 7.0 ± 5.8 c | 23.0 ± 10.0 c | 205.0 ± 2.6 a |
| 104 | 0.0 ± 0.0 c | 13.0 ± 5.8 c | 33.0 ± 5.8 c | 201.0 ± 1.4 a | |
| 105 | 0.0 ± 0.0 c | 13.0 ± 15.3 bc | 57.0 ± 5.8 b | 172.0 ± 2.1 b | |
| 106 | 3.4 ± 5.8 b | 20.0 ± 10.0 b | 60.0 ± 10.0 a | 170.0 ± 1.2 b | |
| 107 | 10.0 ± 10.0 a | 33.0 ± 11.5 a | 73.0 ± 11.5 a | 132.0 ± 1.8 c | |
| 108 | 23.0 ± 15.3 a | 43.0 ± 15.3 a | 77.0 ± 5.8 a | 124.0 ± 0.9 d | |
| Control | H2O + Tergitol Np9 | 0.0 ± 0.0 c | 0.0 ± 0.0 d | 2.7 ± 1.3 d | 215.0 ± 0.2 e |
| Treatment | Concentration | Exposure Time | Median Lethal Time | ||
|---|---|---|---|---|---|
| 72 HAT | 144 HAT | 216 HAT | |||
| F. tonkinense | 103 | 0.0 ± 0.0 c | 10.0 ± 5.8 c | 20.0 ± 10.0 c | 205.0 ± 0.6 a |
| 104 | 0.0 ± 0.0 c | 13.0 ± 3.8 c | 23.0 ± 5.8 c | 203.0 ± 1.7 a | |
| 105 | 0.0 ± 0.0 c | 13.0 ± 12.3 bc | 37.0 ± 5.8 b | 195.0 ± 2.1 b | |
| 106 | 3.4 ± 5.8 b | 20.0 ± 10.0 b | 50.0 ± 10 a | 177.0 ± 0.2 c | |
| 107 | 10.0 ± 10.0 a | 23.0 ± 11.5 a | 67.0 ± 11.5 a | 162.0 ± 2.8 d | |
| 108 | 13.0 ± 15.3 a | 33.0 ± 15.3 a | 71.0 ± 5.8 a | 158.0 ± 0.9 e | |
| Control | H2O + Tergitol Np9 | 0.0 ± 0.0 c | 0.0 ± 0.0 d | 2.7 ± 1.3 d | 215.0 ± 0.2 f |
| Treatment | Concentration | Exposure Time | Median Lethal Time | ||
|---|---|---|---|---|---|
| 72 HAT | 144 HAT | 216 HAT | |||
| F. longifundum | 103 | 0.0 ± 0.0 c | 13.0 ± 5.8 c | 13.0 ± 5.8 c | 208.0 ± 0.6 a |
| 104 | 0.0 ± 0.0 c | 17.0 ± 5.8 c | 23.0 ± 5.8 c | 202.0 ± 3.7 b | |
| 105 | 3.4 ± 5.8 b | 27.0 ± 15.3 bc | 37.0 ± 5.8 b | 193.0 ± 3.3 c | |
| 106 | 3.4 ± 5.8 b | 33.0 ± 10 b | 40.0 ± 10.0 a | 187.0 ± 2.2 d | |
| 107 | 6.7 ± 10 a | 37.0 ± 11.5 a | 46.0 ± 11.5 a | 182.0 ± 1.8 e | |
| 108 | 13.0 ± 15.3 d | 40.0 ± 15.3 a | 67.0 ± 5.8 a | 161.0 ± 2.9 f | |
| Control | H2O + Tergitol Np9 | 0.0 ± 0.0 c | 0.0 ± 0.0 d | 2.7 ± 1.3 d | 215.0 ± 0.2 g |
| Treatment | Concentration | Exposure Time | Median Lethal Time | ||
|---|---|---|---|---|---|
| 72 HAT | 144 HAT | 216 HAT | |||
| F. pseudoanthophilum | 103 | 0.0 ± 0.0 c | 7.0 ± 5.8 d | 13.0 ± 5.8 e | 208.0 ± 0.3 a |
| 104 | 3.4 ± 5.8 a | 17.0 ± 11.5 c | 27.0 ± 15.3 d | 189.0 ± 2.1 b | |
| 105 | 3.4 ± 5.8 a | 23.0 ± 15.3 c | 47.0 ± 15.3 cd | 157.0 ± 2.3 c | |
| 106 | 3.4 ± 5.8 a | 33.0 ± 5.8 b | 57.0 ± 5.8 c | 148.0 ± 1.2 d | |
| 107 | 10.0 ± 10.0 b | 37.0 ± 11.5 ab | 67.0 ± 5.8 b | 132.0 ± 3.8 e | |
| 108 | 20.0 ± 0.0 d | 40.0 ± 10.0 a | 81.0 ± 5.8 a | 106.0 ± 1.9 f | |
| Control | H2O + Tergitol Np9 | 0.0 ± 0.0 c | 0.0 ± 0.0 e | 2.7 ± 1.3 f | 215.0 ± 0.2 g |
| Treatment | Concentration | Exposure Time | Median Lethal Time | ||
|---|---|---|---|---|---|
| 72 HAT | 144 HAT | 216 HAT | |||
| F. fujikuroi | 103 | 0.0 ± 0.0 c | 10.0 ± 10.0 b | 17.0 ± 5.8 d | 205.0 ± 1.3 a |
| 104 | 10.0 ± 10.0 ab | 23.0 ± 11.5 b | 40.0 ± 10.0 c | 182.0 ± 3.1 b | |
| 105 | 10.0 ± 5.8 b | 33.0 ± 0.0 b | 50.0 ± 0.0 c | 175.0 ± 1.4 c | |
| 106 | 10.0 ± 10.0 ab | 40.0 ± 10.0 b | 60.0 ± 10.0 b | 160.0 ± 1.2 d | |
| 107 | 13.0 ± 0.0 a | 53.0 ± 20.8 a | 73.0 ± 5.8 a | 150.0 ± 1.8 e | |
| 108 | 20.0 ± 5.8 b | 56.7 ± 5.8 a | 77.0 ± 0.0 a | 145.0 ± 2.1 f | |
| Control | H2O + Tergitol Np9 | 0.0 ± 0.0 c | 0.0 ± 0.0 c | 2.7 ± 1.3 e | 215.0 ± 0.2 g |
| Treatment | Concentration | Exposure Time | Median Lethal Time | ||
|---|---|---|---|---|---|
| 72 HAT | 144 HAT | 216 HAT | |||
| F. algeriense | 103 | 6.7 ± 5.8 b | 6.7 ± 5.8 b | 10.0 ± 10.0 d | 209.0 ± 0.3 a |
| 104 | 6.7 ± 5.8 b | 13.0 ± 11.5 b | 20.0 ± 10.0 c | 204.0 ± 2.1 b | |
| 105 | 6.7 ± 5.8 b | 20.0 ± 0.0 a | 30.0 ± 0.0 c | 192.0 ± 1.4 c | |
| 106 | 10.0 ± 10.0 ab | 26.0 ± 10.0 a | 43.0 ± 10.0 b | 185.0 ± 2.2 d | |
| 107 | 10.0 ± 0.0 ab | 33.0 ± 20.8 ac | 53.0 ± 5.8 a | 179.0 ± 2.8 e | |
| 108 | 13.0 ± 5.8 a | 36.7 ± 5.8 c | 60.0 ± 0.0 a | 162.0 ± 1.1 f | |
| Control | H2O + Tergitol Np9 | 0.0 ± 0.0 c | 0.0 ± 0.0 d | 2.7 ± 1.3 e | 215.0 ± 0.2 g |
| Fungal Isolate | df | LC50 (±95% CI) | Slope ± SE | Intercept | χ2 | p |
|---|---|---|---|---|---|---|
| F. solani | 5 | 3.88 × 103 (7.22 × 102–4.47 × 104) | 1.54 ± 0.70 | 0.133 | 1.53 | 0.74 |
| F. chlamydosporum var. chlamydosporum | 5 | 2.13 × 104 (8.25 × 103–1.07 × 105) | 2.74 ± 0.13 | 0.033 | 2.74 | 0.90 |
| F. tonkinense | 5 | 1.19 × 106 (0.9 × 105–1.4 × 107) | 3.94 ± 0.21 | −1.033 | 3.09 | 0.82 |
| F. longifundum | 5 | 2.17 × 106 (1.2 × 105–3.2 × 107) | 4.13 ± 0.13 | −1.166 | 3.20 | 0.96 |
| F. pseudoanthophilum | 5 | 8.96 × 105 (2.2 × 104–5.4 × 105) | 3.15 ± 0.13 | −0.013 | 2.81 | 0.88 |
| F. fujikuroi | 5 | 7.85 × 105 (2.8 × 104–4.6 × 105) | 4.43 ± 0.47 | −2.266 | 3.23 | 0.93 |
| F. algeriense | 5 | 11.85 × 106 (5.2 × 105–9.4 × 107) | 4.97 ± 0.38 | −1.866 | 4.20 | 0.97 |
Publisher’s Note: MDPI stays neutral with regard to jurisdictional claims in published maps and institutional affiliations. |
© 2022 by the authors. Licensee MDPI, Basel, Switzerland. This article is an open access article distributed under the terms and conditions of the Creative Commons Attribution (CC BY) license (https://creativecommons.org/licenses/by/4.0/).
Share and Cite
Mantzoukas, S.; Kitsiou, F.; Lagogiannis, I.; Eliopoulos, P.A. Potential Use of Fusarium Isolates as Biological Control Agents: Helicoverpa armigera (Hübner) (Lepidoptera: Noctuidae) Case Study. Appl. Sci. 2022, 12, 8918. https://doi.org/10.3390/app12178918
Mantzoukas S, Kitsiou F, Lagogiannis I, Eliopoulos PA. Potential Use of Fusarium Isolates as Biological Control Agents: Helicoverpa armigera (Hübner) (Lepidoptera: Noctuidae) Case Study. Applied Sciences. 2022; 12(17):8918. https://doi.org/10.3390/app12178918
Chicago/Turabian StyleMantzoukas, Spiridon, Foteini Kitsiou, Ioannis Lagogiannis, and Panagiotis A. Eliopoulos. 2022. "Potential Use of Fusarium Isolates as Biological Control Agents: Helicoverpa armigera (Hübner) (Lepidoptera: Noctuidae) Case Study" Applied Sciences 12, no. 17: 8918. https://doi.org/10.3390/app12178918
APA StyleMantzoukas, S., Kitsiou, F., Lagogiannis, I., & Eliopoulos, P. A. (2022). Potential Use of Fusarium Isolates as Biological Control Agents: Helicoverpa armigera (Hübner) (Lepidoptera: Noctuidae) Case Study. Applied Sciences, 12(17), 8918. https://doi.org/10.3390/app12178918